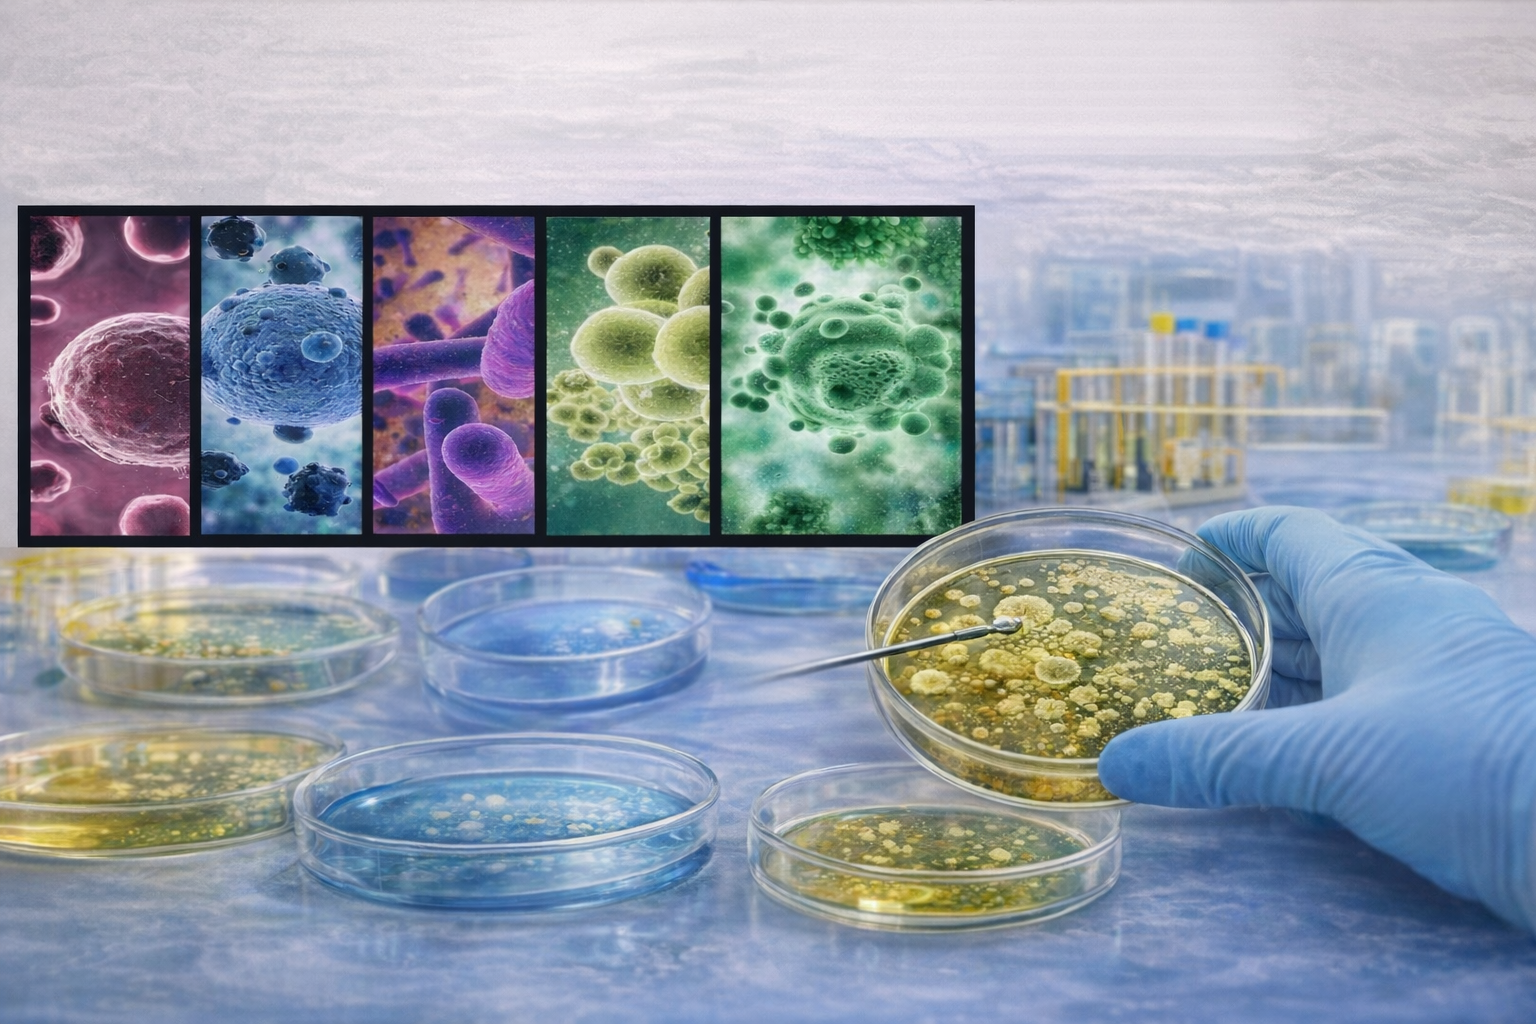
LIES

La EM desarrolla una sola Línea de Generación y Aplicación del Conocimiento (LGAC): Microbiología Médica y Ambiental, cuyo objetivo fundamental es formar recursos humanos con alta capacidad para el ejercicio profesional en los ámbitos del diagnóstico de microorganismos patógenos que afecten la salud humana, de plantas y animales.
En el aspecto de la especialización de dichos recursos humanos, al posgrado del Centro de Investigación Especializada en Microbiología le compete formarlos para que manejen y apliquen métodos de diagnóstico no convencionales que permitan resolver, en sus respectivos ámbitos, la problemática que frena el desarrollo del estado de Guerrero.
Sin embargo, los proyectos se vinculan a Líneas de Investigación e Incidencia Social (LIES) propuestas por los miembros del Núcleo Académico.